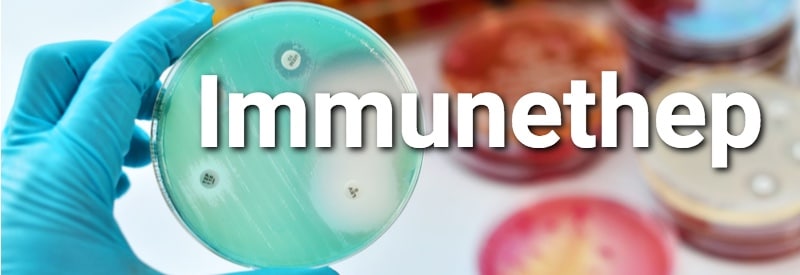

Portuguese hotels applaud EU approval to do away with quarantines and tests for Covid Digital Certificate holders
The Portuguese Association of Hotels (AHP) has applauded the European Council’s recommendation to allow the free circulation of citizens with a valid Covid Digital Certificate within the EU, meaning they
75% of Portugal’s ‘Covid hospital patients’ admitted for other reasons
A television interview with virologist Pedro Simas last night revealed that 75% of people admitted to hospitals and classified in official bulletins as suffering from Covid were actually admitted for
Lagos’ São Gonçalo hospital becomes ‘exclusively’ available to SNS public health service
Lagos’ formerly private São Gonçalo hospital has from today become integrated within the Algarve chain of State-run hospitals (CHUA, standing for Centro Hospitalar Universitário do Algarve). The move opens up
EU agrees to “do away with tests and quarantines for citizens with Covid Digital Certificates”
Even though it is well-accepted now that the fully-jabbed (and boosted) can transmit the virus, and become infected, Member States of the EU today have “agreed that anyone with a
Complementary exams needed before authorities can give results on tragic Rodrigo’s post-Covid vaccine death
Authorities have said they cannot give the results of the post-mortem of the six-year-old child who died following his first shot of mRNA Covid vaccine, as “complementary exams” are needed,
Death of six-year-old child: Infarmed confirms notification of suspicion of adverse reaction to vaccine
The death of a six-year-old boy in Lisbon on Sunday following “notification of a suspected adverse reaction” to the Covid vaccine is under investigation. Medicines authority Infarmed has said: “We
Specialists call for change in way Covid is ‘monitored’ in Portugal
Specialists are calling time on the daily Covid bulletins that bombard citizens with numbers every day. An article in Expresso this weekend explains that Omicron has changed the landscape. “It
Covid incidence nationally up to 3,796 cases per 100,000; Lisbon sees 5,000
In many ways today is another ‘black day’ when it comes to numbers: another 40,090 new cases of Covid infection; a leap in the daily death toll to 34 (the
Portuguese Covid vaccine stymied through lack of funding
A little like the ‘miracle’ of a repurposed drug to reduce the effects of Covid-19, Portuguese scientific solutions to the pandemic continue to be sidelined by authorities. Today, Bruno Santos,
Lagoa opens new Covid-19 testing centre at Fatacil
Lagoa Council has announced the opening of a Covid-19 testing centre at the Fatacil fairground. The testing centre opens tomorrow (Friday, January 7) and will allow local citizens to carry